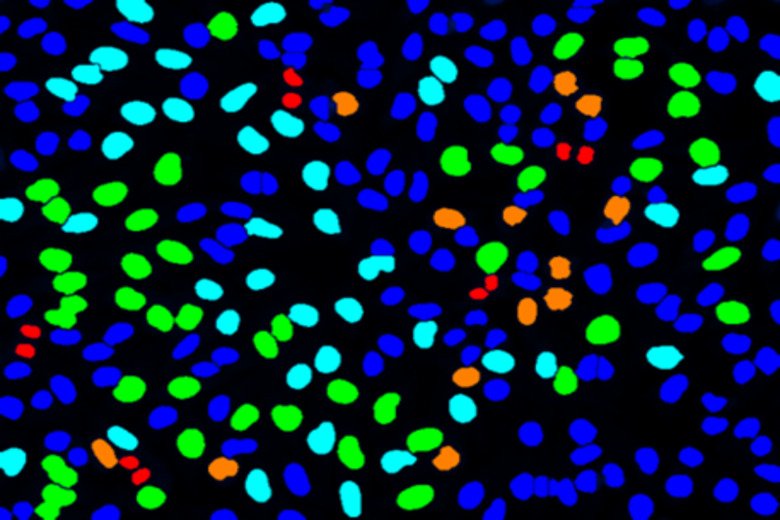
Image from Biomedicum Imaging Core. Credit: Florian Salomons.

Forskargruppledare A-Ö & forskargrupper - CNS Neuro
Här listas forskargruppledare vid institutionen för klinisk neurovetenskap avdelningen för Neuro i bokstavsordning samt deras respektive forskargrupp/forskningsområde
För respektive forskningsområde i bokstavsordning, klicka här
Forskargruppsledare A-Ö
 Foto: Dpt of Neuroscience,Lennart Nilsson
Foto: Dpt of Neuroscience,Lennart NilssonNiaz Ahmeds forskargrupp
Stroke - Akut intervention och sekundärprevention
 Foto: Photografer at CNS
Foto: Photografer at CNSLou Brundins forskargrupp
Stamceller och inflammation
Påverkan på stamceller vid inflammation i nervsystemet
 Foto: Mattias Günther
Foto: Mattias GüntherCharith Coorays forskargrupp
Klinisk neurofysiologi
Neurofysiologiska tekniker spelar fortfarande en stor roll för att upptäcka funktionsstörningar i hjärnan. Dessa metoder möjliggör en omedelbar ögonblicksbild av olika fysiologiska parametrar, vare sig de är elektrofysiologiska eller hemodynamiska.
 Foto: Getty Images
Foto: Getty ImagesErik Edströms och Adrian Elmi Teranders forskargrupp
Augmenterad neurokirurgi.
Vår forskargrupp utvecklar lösningar och teknologier för att öka precisionen i kirurgiska ingrepp i syfte att förbättra kirurgiska resultat och minska frekvensen av patientskador, omoperationer och längden på sjukhusvistelse.
 Foto: Getty images,Getty Images/iStockphoto
Foto: Getty images,Getty Images/iStockphotoAnna Falk Delgados forskagrupp
Kliniska hjärnavbildningsmetoder
 Foto: Getty Images
Foto: Getty ImagesPeter Franssons forskargrupp
Hjärnans strukturella och funktionella nätverksarkitektur och dess relation till beteende och sjukdom i nervsystemet

Anna Glasers forskargrupp
Real-world-data i multipel skleros
 Foto: Tobias Granberg
Foto: Tobias GranbergTobias Granbergs forskargrupp
Neuroradiologi: neurodegeneration och neuroinflammation
 Foto: Ujjwal Neogi
Foto: Ujjwal NeogiRobert Harris forskargrupp
Immunoterapi.
Vi strävar efter att tillämpa nya behandlingsmetoder som kommer från experimentella studier till människans kliniska miljö.
Foto: Florian Salomons
Foto: Florian SalomonsStaffan Holmins forskargrupp
Neuroradiologi.
Staffan Holmins forskargrupp är en del av Institutionen för Klinisk Neurovetenskap på Karolinska Institutet och Neuroradiologiska kliniken på Karolinska Universitetssjukhuset. Gruppen arbetar med klinisk och translationell forskning inom flera ämnen relaterade till modern neuroimaging, nuklearmedicin och vaskulära interventioner.
 Foto: N/A
Foto: N/ACaroline Ingres forskargrupp
ALS
ALS (amyotrofisk lateral skleros) är en dödlig neuromuskulär sjukdom som kännetecknas av degeneration av de övre och nedre motorneuronen.
 Foto: N/A
Foto: N/AMaja Jagodics forskargrupp
Funktionell (epi)genomik vid neuroinflammatoriska sjukdomar
 Foto: N/A
Foto: N/AKarin Jensens forskargrupp
Smärta och hjärnavbildning.
Hur ser hjärnans aktivitet ut under smärta?
 Foto: Ada Delaney och Camilla Svensson
Foto: Ada Delaney och Camilla SvenssonEva Koseks forskargrupp
Mekanismer för smärta och behandling
Vår forskning undersöker interaktionen mellan nerv- och immunsystemet med avseende på utvecklingen av kronisk smärta.
 Foto: GettyImages
Foto: GettyImagesDaniel Lundqvists forskargrupp
Multimodal hjärnavbildning
 Foto: N/A
Foto: N/AKyla McKay och Katarina Finks forskargrupp
Neuroepidemiologi
 Foto: N/A
Foto: N/AJoana Pereiras forskargrupp
Hjärnans konnektivitet
 Foto: Amagoia Agirre
Foto: Amagoia AgirreFredrik Piehls forskargrupp
Klinisk neuroimmunologi och immunmodulering
 Foto: N/A
Foto: N/AStefan Skares forskargrupp
Neuroradiologi – MR-fysik
Forskargruppen består av MR-fysiker på Karolinska Universitetssjukhuset och GE Healthcare som gemensamt bedriver utveckling av nya bildtagningsmetoder för MR (magnetkamera) inom neuroradiologi.
 Foto: N/A
Foto: N/AIngrid Skelton Kockums forskargrupp
Genetisk epidemiologi av multipel skleros.
Vårt mål är att identifiera genetiska riskfaktorer för multipel skleros, studera deras funktion och hur de tillsammans med riskfaktorer för multipel skleros i livsstilen samverkar.
 Foto: N/A
Foto: N/APer Svenningssons forskargrupp
Neurofarmakologi - rörelsesjukdomar
 Foto: Getty Images
Foto: Getty ImagesMikael A. Svenssons forskargrupp
Neurokirurgi
Reparation av skador i CNS med mikrokirurgi och stamcellsteknik.
 Foto: Mattias Karlén
Foto: Mattias KarlénEric Thelins forskargrupp
Traumatiska hjärnskador och neuromonitorering
 Foto: Grönlund
Foto: GrönlundOlivia Thomas forskargrupp
Translationell immunologi vid neuroinflammation.
Vårt forskningsfokus är diagnos och botande behandling av kroniskt inflammatoriska sjukdomar och cancer.
